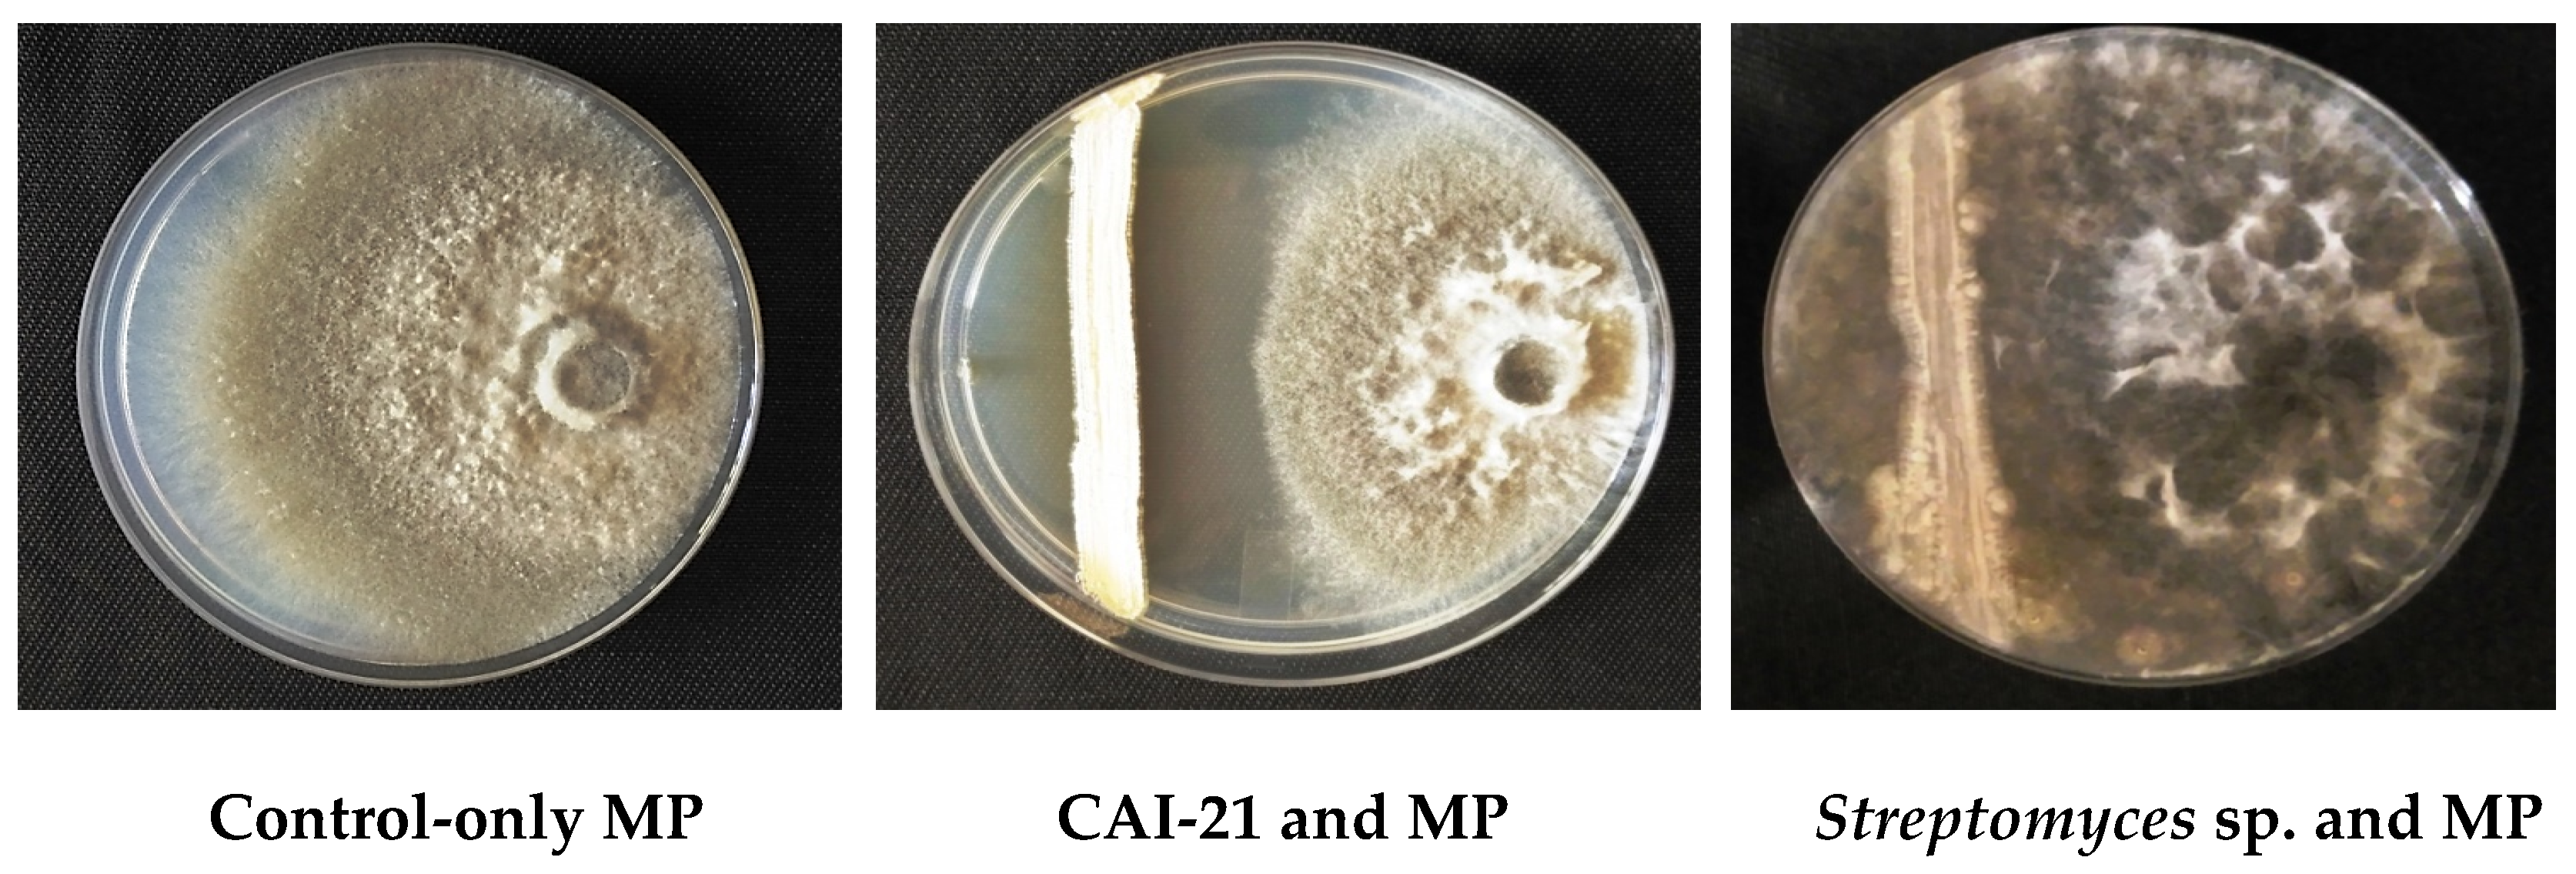
Plants 09 01727 g001
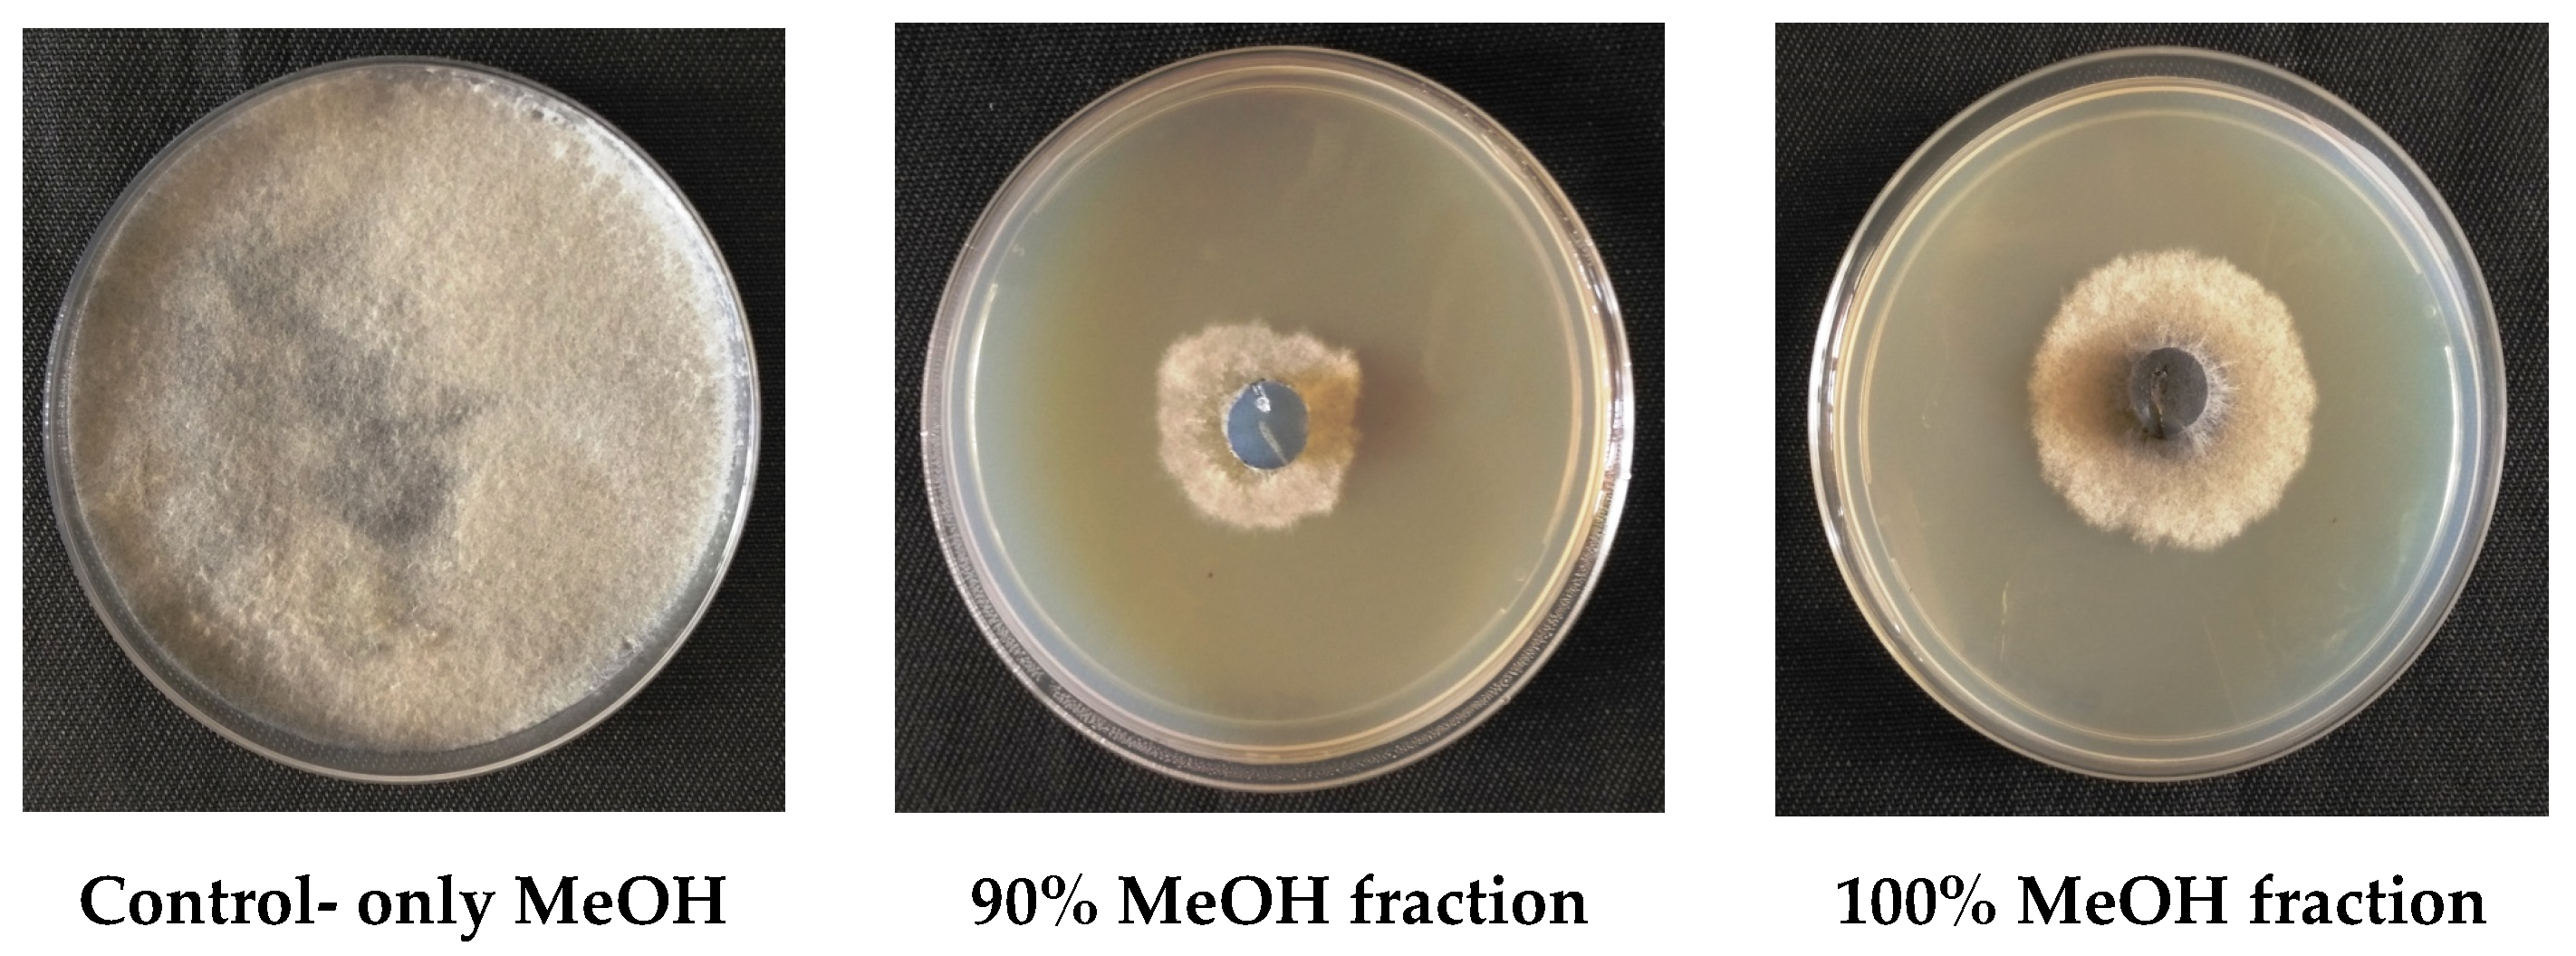
Plants 09 01727 g006

Identification and Characterization of a Streptomyces albus Strain and Its Secondary Metabolite Organophosphate against Charcoal Rot of Sorghum
Abstract
1. Introduction
2. Results and Discussion
2.1. In Vitro Inhibitory Activity of S. albus CAI-21
2.2. In Vivo Biocontrol Potential of S. albus CAI-21
2.3. Greenhouse and Field Trials
2.4. Purification of the Active Secondary Metabolite from S. albus CAI-21
2.5. Identification of the Active Secondary Metabolite from S. albus CAI-21
3. Materials and Methods
3.1. PGP Microbe
3.2. In Vitro Dual-Culture and Secondary Metabolite Production Assays
3.3. In Vivo Blotter Paper Assay
3.4. Greenhouse Trials
3.5. Field Trials
3.6. Purification and Identification of Active Metabolite from S. albus CAI-21
3.7. Characterization of the Purified Compound
3.7.1. Mass Spectrometry (MS)
3.7.2. Nuclear Magnetic Resonance (NMR)
3.8. Statistical Analysis
4. Conclusions
Supplementary Materials
Author Contributions
Funding
Acknowledgments
Conflicts of Interest
References
- Proietti, I.; Frazzoli, C.; Mantovani, A. Exploiting nutritional value of staple foods in the world’s semi-arid areas: Risks, benefits, challenges and opportunities of sorghum. Healthcare 2015, 3, 172–193. [Google Scholar] [CrossRef] [PubMed]
- FAOSTAT. Statistical Database 2018. Available online: http://faostat.fao.org (accessed on 20 September 2020).
- Patil, V.; Kamble, S. The influence of ultraviolet light on antagonistic activity of Trichoderma koningii against Macrophomina phaseolina causing charcoal rot of sweet potato. Int. J. Acad. Res. 2011, 3, 702–704. [Google Scholar]
- Kaur, S.; Dhillon, G.S.; Brar, S.K.; Vallad, G.E.; Chand, R.; Chauhan, V.B. Emerging phytopathogen Macrophomina phaseolina: Biology, economic importance and current diagnostic trends. Crit. Rev. Microbiol. 2012, 38, 136–151. [Google Scholar] [CrossRef] [PubMed]
- Khan, K.A.; Shoaib, A.; Awan, Z.A.; Basit, A.; Hussain, M. Macrophomina phaseolina alters the biochemical pathway in Vigna radiata chastened by Zn2+ and FYM to improve plant growth. J. Plant Interact. 2018, 13, 131–140. [Google Scholar] [CrossRef]
- ICRISAT (International Crops Research Institute for the Semi-Arid Tropics). Sorghum root and stalk rots, a critical review. In Proceedings of the Consultative Group Discussion on Research Needs and Strategies for Control of Sorghum Root and Stalk Rot Diseases, Bellagio, Italy, 27 November–2 December 1983; Patancheru, A.P., Ed.; ICRISAT (International Crops Research Institute for the Semi-Arid Tropics): Patancheru, India, 1984. [Google Scholar]
- Goudarzi, A.; Banihashemi, Z.; Maftoun, M. Effect of salt and water stress on root infection by Macrophomina phaseolina and ion composition in shoot in sorghum. Iran J. Plant Pathol. 2011, 47, 69–83. [Google Scholar]
- Baird, R.E.; Wadl, P.A.; Wang, X.; Johnson, D.H.; Rinehart, T.A.; Abbas, H.K.; Shier, T.; Trigiano, R.N. Microsatellites from the charcoal rot fungus (Macrophomina phaseolina). Mol. Ecol. 2009, 9, 946–948. [Google Scholar] [CrossRef] [PubMed]
- Mahdizadeh, V.; Safaie, N.; Goltapeh, E.M. Diversity of Macrophomina phaseolina based on morphological and genotypic characteristics in Iran. Plant Pathol. 2011, 27, 128–137. [Google Scholar] [CrossRef][Green Version]
- Ghosh, T.; Biswas, M.K.; Guin, C.; Roy, P.A. Review on characterization, therapeutic approaches and pathogenesis of Macrophomina phaseolina. Plant Cell Biotechnol. Mol. Biol. 2018, 19, 72–84. [Google Scholar]
- Manjeet, A.; Umesh, D. Biochemical control of charcoal rot of Sorghum bicolor (L.) Moench. Int. J. Curr. Microbiol. App. Sci. 2013, 2, 19–23. [Google Scholar]
- Das, I.K.; Rakshit, S.; Sharma, K.K.; Chattannavar, S.N.; Gholve, V.M.; Jayalaksmi, S.K.; Tonapi, V.A. Development of a charcoal rot rating index for multilocation trials of sorghum. Crop Prot. 2018, 108, 102–109. [Google Scholar] [CrossRef]
- Alekhya, G.; Sharma, R.; Gopalakrishnan, S. Streptomyces spp., a potential biocontrol agent of charcoal rot of sorghum caused by Macrophomina phaseolina. Ind. J. Plant Protect. 2016, 44, 1–7. [Google Scholar]
- Khaledi, N.; Taheri, P. Biocontrol mechanisms of Trichoderma harzianum against soybean charcoal rot caused by Macrophomina phaseolina. J. Plant Protect. Res. 2016, 56, 21–31. [Google Scholar] [CrossRef]
- Torres, M.J.; Brandan, C.P.; Petroselli, G.; Erra-Balsells, R.; Audisio, M.C. Antagonistic effects of Bacillus subtilis subsp. subtilis and B. amyloliquefaciens against Macrophomina phaseolina: SEM study of fungal changes and UV-MALDI-TOF MS analysis of their bioactive compounds. Microbiol. Res. 2016, 182, 31–39. [Google Scholar] [CrossRef] [PubMed]
- Dey, S.; Dutta, P.; Majumdar, S. Biological control of Macrophomina phaseolina in Vigna mungo L. by endophytic Klebsiella pneumoniae HR1. Jordan J. Biol. Sci. 2019, 12, 219–227. [Google Scholar]
- Gopalakrishnan, S.; Srinivas, V.; Naresh, N.; Alekhya, G.; Sharma, R. Exploiting plant growth-promoting Amycolatopsis sp. for bio-control of charcoal rot of sorghum (Sorghum bicolor L.) caused by Macrophomina phaseolina (Tassi) Goid. Arch. Phytopathol. Plant Protect. 2019, 52, 543–559. [Google Scholar] [CrossRef]
- Gopalakrishnan, S.; Kiran, B.K.; Humayun, P.; Vidya, M.S.; Deepthi, K.; Rupela, O. Biocontrol of charcoal-rot of sorghum by actinomycetes isolated from herbal vermicompost. Afric. J. Biotechnol. 2011, 10, 18142–18152. [Google Scholar]
- Gopalakrishnan, S.; Humayun, P.; Srinivas, S.; Vijayabharathi, R.; Ratnakumari, B.; Rupela, O. Plant growth-promoting traits of biocontrol potential Streptomyces isolated from herbal vermicompost. Biocont. Sci. Technol. 2012, 22, 1199–1210. [Google Scholar] [CrossRef]
- Gopalakrishnan, S.; Srinivas, V.; Alekhya, G.; Prakash, B.; Kudapa, H.; Varshney, R.K. Evaluation of broad-spectrum Streptomyces sp. for plant growth-promotion traits in chickpea. Philipp. Agric. Sci. 2015, 98, 270–278. [Google Scholar]
- Gopalakrishnan, S.; Vadlamudi, S.; Kumar, C.V.S. Plant growth-promoting traits of Streptomyces sp. in pigeonpea. Leg. Perspec. 2016, 11, 43–44. [Google Scholar]
- Gopalakrishnan, S.; Thakur, V.; Saxena, R.K.; Vadlamudi, S.; Purohit, S.; Kumar, V.; Rathore, A.; Chitikineni, A.; Varshney, R.K. Complete genome sequence of sixteen plant growth-promoting Streptomyces strains. Sci. Rep. 2020, 10, 10294. [Google Scholar]
- Sathya, A.; Vijayabharathi, R.; Srinivas, V.; Gopalakrishnan, S. Plant growth-promoting actinobacteria on chickpea seed mineral density: An upcoming complementary tool for sustainable biofortification strategy. 3Biotech 2016, 6, 1–6. [Google Scholar] [CrossRef] [PubMed]
- Alekhya, G.; Gopalakrishnan, S. Biological ccontrol and plant growth-promotion traits of Streptomyces species under greenhouse and field conditions in chickpea. Agric. Res. 2017, 6, 410–420. [Google Scholar] [CrossRef]
- Kim, Y.J.; Kim, J.H.; Rho, J.Y. Antifungal activities of Streptomyces blastmyceticus Strain 12-6 against plant pathogenic fungi. Mycobiology 2019, 49, 329–334. [Google Scholar] [CrossRef] [PubMed]
- Kumar, P.; Thakur, S.; Dhingra, G.K.; Singh, A.; Pal, M.; Harshvardhan, K.; Dubey, R.C.; Maheshwari, D. Inoculation of siderophore producing rhizobacteria and their consortium for growth enhancement of wheat plant. Biocat. Agric. Biotech. 2018, 15, 264–269. [Google Scholar] [CrossRef]
- Abo-Elyousr, K.A.M.; Bagy, H.M.M.K.; Hashem, M.; Almari, S.A.M.; Mostafa, Y.S. Biological control of the tomato wilt caused by Clavibacter michiganensis sub sp. michiganensis using formulated plant growth-promoting bacteria. Egypt J. Biol. Pest Control 2019, 29, 54. [Google Scholar] [CrossRef]
- Schlaeppi, K.; Bulgarelli, D. The plant microbiome at work. Mol. Plant Microbe. Interact. 2015, 28, 212–217. [Google Scholar] [CrossRef]
- Shrivastava, P.; Kumar, R.; Yandigeri, M.S. In vitro biocontrol activity of halotolerant Streptomyces aureofaciens K20: A potent antagonist against Macrophomina phaseolina (Tassi) Goid. Saudi J. Biol. Sci. 2017, 24, 192–199. [Google Scholar] [CrossRef][Green Version]
- Hassan, M.K.; McInroy, J.A.; Kloepper, J.W. The interactions of rhizodeposits with plant growth-promoting rhizobacteria in the rhizosphere. Rev. Agric. 2019, 9, 142. [Google Scholar] [CrossRef]
- Khan, N.; Bano, A.; Ali, S.; Ali, B.M. Crosstalk amongst phytohormones from planta and PGPR under biotic and abiotic stresses. Plant Growth Regul. 2020, 90, 189–203. [Google Scholar] [CrossRef]
- Musilova, L.; Ridl, J.; Polivkova, M.; Macek, T.; Uhlik, O. Effects of secondary plant metabolites on microbial populations: Changes in community structure and metabolic activity in contaminated environments. Int. J. Mol. Sci. 2016, 17, 1205. [Google Scholar] [CrossRef]
- Lushchak, V.I.; Matviishyn, T.M.; Husak, V.V.; Storey, J.M.; Storey, K.B. Pesticide toxicity: A mechanistic approach. EXCLI J. 2018, 17, 1101–1136. [Google Scholar] [PubMed]
- Archer, T.L.; Segarra, E.; Bynum, E.D., Jr. Greenbug resistance management of sorghum with insecticide mixtures: A biological and economic analysis. J. Econ. Entomol. 1999, 92, 794–803. [Google Scholar] [CrossRef]
- Daglish, G.J.; Wallbank, B.E.; Nayak, M.K. Synergized Bifenthrin plus Chlorpyrifos-Methyl for control of beetles and Psocids in sorghum in Australia. J. Econ. Entomol. 2003, 96, 525–532. [Google Scholar] [CrossRef] [PubMed]
- Samota, M.K.; Priyanka, J.; Seth, G. Synthesis, characterization and biological activity of organophosphates derived from substituted Benzoxazole. Heteroat. Chem. 2009, 20, 232–234. [Google Scholar] [CrossRef]
- Fiore, M.F.; de Lima, S.T.; Carmichael, W.W.; McKinnie, S.M.K.; Chekan, J.R.; Moore, B.S. Guanitoxin, re-naming a cyanobacterial organophosphate toxin. Harmful Algae 2020, 92, 101737. [Google Scholar] [CrossRef] [PubMed]
- Petkowski, J.J.; Bains, W.; Seager, S. Natural Products Containing ‘Rare’ Organophosphorus Functional Groups. Molecules 2019, 24, 866. [Google Scholar] [CrossRef] [PubMed]
- Neumann, R.; Peter, H.H. Insecticidal organophosphates: Nature made them first. Experientia 1987, 43, 1235–1237. [Google Scholar] [CrossRef]
- Kurokawa, T.; Suzuki, K.; Hayaoka, T.; Nakagawa, T.; Izawa, T.; Kobayashi, M.; Harada, N. Cyclophostin, acetylcholinesterase inhibitor from Streptomyces lavendulae. J. Antibiot. Res. 1993, 46, 1315–1318. [Google Scholar] [CrossRef]
- Quitschau, M.; Schuhmann, T.; Piel, J.; Zezschwitz, P.; Grond, S. The new metabolite (S)-Cinnamoylphosphoramide from Streptomyces sp. and its total synthesis. Eur. J. Org. Chem. 2008, 2008, 5117–5124. [Google Scholar] [CrossRef]
- McGrath, J.; Chin, J.; Quinn, J. Organophosphonates revealed: New insights into the microbial metabolism of ancient molecules. Nat. Rev. Microbiol. 2013, 11, 412–419. [Google Scholar] [CrossRef]
- Sharma, D.; Mayilraj, S.; Manhas, R.K. Streptomyces amritsarensis sp. nov., exhibiting broad-spectrum antimicrobial activity. Antonie Leeuwenhoek 2014, 105, 943–949. [Google Scholar] [CrossRef] [PubMed]
- Aggarwal, N.; Thind, S.K.; Sharma, S. Role of secondary metabolites of actinomycetes in crop protection. In Plant Growth-Promoting Actinobacteria; Gopalakrishnan, S., Sathya, A., Vijayabharathi, R., Eds.; Springer: Singapore, 2016; pp. 99–122. [Google Scholar]
- Gopalakrishnan, S.; Vijayabharathi, R.; Sathya, A.; Sharma, H.C.; Srinivas, V.; Bhimineni, R.K.; Gonzalez, S.V.; Melø, T.M.; Simic, N. Insecticidal activity of a novel fatty acid amide derivative from Streptomyces species against Helicoverpa armigera. Nat. Prod. Res. 2016, 30, 2760–2769. [Google Scholar] [CrossRef] [PubMed][Green Version]
- Cao, P.; Li, C.; Wang, H.; Yu, Z.; Xu, X.; Wang, X.; Zhao, J.; Xiang, W. Community structures and antifungal activity of root-associated endophytic actinobacteria in healthy and diseased cucumber plants and Streptomyces sp. HAAG3-15 as a promising biocontrol agent. Microorganisms 2020, 8, 236. [Google Scholar] [CrossRef] [PubMed]
- Gopalakrishnan, S.; Humayun, P.; Kiran, B.K.; Kannan, I.G.K.; Vidya, M.S.; Deepthi, K.; Rupela, O. Evaluation of bacteria isolated from rice rhizosphere for biological control of sorghum caused by M. phaseolina. World J. Microbiol. Biotechnol. 2011, 27, 1313–1321. [Google Scholar] [CrossRef] [PubMed]
- Westley, J.W.; Evans, R.H., Jr.; Sello, L.H.; Troupe, N.; Liu, C.M.; Blount, J.F. Isolation and characterization of antibiotic X-14547 A, a novel monocarboxylic acid ionophore produced by Streptomyces antibioticus NRRL 8167. J. Antibiot. 1979, 32, 100–107. [Google Scholar] [CrossRef] [PubMed]
- Nene, Y.L.; Haware, M.P.; Reddy, M.V. Chickpea diseases: Resistance-screening techniques. ICRISAT Inf. Bull. 1981, 10, 5–7. [Google Scholar]
- Thakur, R.P.; Reddy, B.V.S.; Mathur, K. (Eds.) Screening techniques for sorghum diseases. In Information Bulletin No. 76; International Crops Research Institute for the Semi-Arid Tropics: Andhra Pradesh, India, 2007; p. 92. ISBN 978-92-9066-504-5. [Google Scholar]
- Bozzolla, J.J.; Russel, L.D. Electron Microscopy Principles and Techniques for Biologists, 2nd ed.; Jones and Barlett Publishers: Sudbury, MA, USA, 1999; pp. 19–24, 54–55, 63–67. ISBN 978-0867201260. [Google Scholar]

| Treatments | Dual-Culture Assay @ | Secondary Metabolite Production Assay # |
|---|---|---|
| CAI-21 + MP | 15 | 73.8 |
| Positive control (only MP) | 0 | 0.0 |
| Negative control (only sterile water) | 0 | 0.0 |
| Chlorpyrifos 20% | - | 68.8 |
| SD | 6.8 | 37.2 |
| LSD (5%) | 0.99 | 2.16 |
| Treatments | Blotter Paper Assay ^ | |
|---|---|---|
| Visual Rating | Root Infection (%) | |
| CAI-21 + MP | 1 | 10 |
| Positive control (only MP) | 4 | 100 |
| Negative control (only sterile water) | 0 | 0 |
| SD | 1.8 | 47.7 |
| LSD (5%) | 0 | 0 |
| Greenhouse | Field | |||
|---|---|---|---|---|
| Treatments | Number of Internodes Infected | Length of Infection (cm) | Number of Internodes Infected | Length of Infection (cm) |
| CAI-21 + MP | 1.0 ** | 3.0 ** | 2.9 *** | 10.0 *** |
| Positive control (only MP) | 4.0 | 12.0 | 5.6 | 19.5 |
| Negative control | 0.0 | 0.0 | 0.0 | 0.0 |
| SD | 1.8 | 5.5 | 2.4 | 8.4 |
| LSD (5%) | 1.24 | 3.29 | 1.36 | 5.04 |
Publisher’s Note: MDPI stays neutral with regard to jurisdictional claims in published maps and institutional affiliations. |
© 2020 by the authors. Licensee MDPI, Basel, Switzerland. This article is an open access article distributed under the terms and conditions of the Creative Commons Attribution (CC BY) license (http://creativecommons.org/licenses/by/4.0/).
Share and Cite
Gopalakrishnan, S.; Sharma, R.; Srinivas, V.; Naresh, N.; Mishra, S.P.; Ankati, S.; Pratyusha, S.; Govindaraj, M.; Gonzalez, S.V.; Nervik, S.; et al. Identification and Characterization of a Streptomyces albus Strain and Its Secondary Metabolite Organophosphate against Charcoal Rot of Sorghum. Plants 2020, 9, 1727. https://doi.org/10.3390/plants9121727
Gopalakrishnan S, Sharma R, Srinivas V, Naresh N, Mishra SP, Ankati S, Pratyusha S, Govindaraj M, Gonzalez SV, Nervik S, et al. Identification and Characterization of a Streptomyces albus Strain and Its Secondary Metabolite Organophosphate against Charcoal Rot of Sorghum. Plants. 2020; 9(12):1727. https://doi.org/10.3390/plants9121727
Chicago/Turabian StyleGopalakrishnan, Subramaniam, Rajan Sharma, Vadlamudi Srinivas, Nimmala Naresh, Suraj P. Mishra, Sravani Ankati, Sambangi Pratyusha, Mahalingam Govindaraj, Susana V. Gonzalez, Sondre Nervik, and et al. 2020. "Identification and Characterization of a Streptomyces albus Strain and Its Secondary Metabolite Organophosphate against Charcoal Rot of Sorghum" Plants 9, no. 12: 1727. https://doi.org/10.3390/plants9121727
APA StyleGopalakrishnan, S., Sharma, R., Srinivas, V., Naresh, N., Mishra, S. P., Ankati, S., Pratyusha, S., Govindaraj, M., Gonzalez, S. V., Nervik, S., & Simic, N. (2020). Identification and Characterization of a Streptomyces albus Strain and Its Secondary Metabolite Organophosphate against Charcoal Rot of Sorghum. Plants, 9(12), 1727. https://doi.org/10.3390/plants9121727

